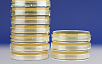

- Биотех
- Каталог
- Питательные среды и контрольные штаммы
- Питательные среды
- Готовые питательные среды в чашках
- Хромогенная питательная среда для определения вибрионов в чашках Петри
Хромогенная питательная среда для определения вибрионов в чашках Петри
- Определение за 24 часа.
- Чашки готовы к применению.
Хромогенная питательная среда для определения вибрионов в чашках Петри
Описание
Vibrio Chromogenic Medium ‒ используется для быстрого обнаружения Vibrio parahaemolyticus в пищевых продуктах, морепродуктах, образцах стула пациентов и воды. После инкубирования Vibrio parahaemolyticus становится сине-зеленым с относительно крупными колониями, Vibrio cholerae и Vibrio vulnificus ‒ пурпурно-красными, Vibrio alginolyticus ‒ бледно-желтыми или бежевыми, большинство других бактерий ингибированы. Среда обладает высокой специфичностью, может превзойти ложноотрицательные результаты, вызванные средой TCBS, и является идеальной средой для быстрого обнаружения.
ИНСТРУКЦИЯ ПО ПРИМЕНЕНИЮ:
Подготовьте раствор образца в соответствии выбранным стандартом. Возьмите 1 мл раствора образца и добавьте 9 мл бульона SCPB или щелочной пептонной воды и инкубируйте при 36 ± 1 °C в течение 18-24 часов.
Используйте инокуляционную петлю чтобы взять обогащенную культуру и инокулируйте её на 2 чашки хромогенной среды. Культивируйте при 36 ± 1 °C в течение 18-24 часов.
ВНЕШНИЙ ВИД:
Готовая среда представляет собой твердое вещество от светло-розового до желтого цвета.
МЕРЫ ПРЕДОСТОРОЖНОСТИ:
Эта среда предназначена только для лабораторного использования.
УСЛОВИЯ ХРАНЕНИЯ И СРОК ГОДНОСТИ:
Готовые чашки хранятся в темноте при температуре 2-8 °С. Срок годности 3 месяца.
| Ингредиенты | г/литр |
| Специальные питательные вещества | 75 г/л |
| Хромогенный реагент | 4,45 г/л |
| Агар | 15 г/л |
| Конечный pH 7,3 ± 0.1 при 25 ℃ | |
Тест на чувствительность микроорганизмов. Инкубируется при 36 ± 1 ℃ в течение 18-24 часов
| Штаммы, отвечающие за контроль качества | Рост | Цвет колоний | |
| Vibrio parahaemolyticus | ATCC17802 | +++ | Зеленые крупные колонии |
| Staphylococcus aureus | ATCC25923 | - | - |
| E. coli | ATCC25922 | +++ | Бесцветные |
| Vibrio alginolyticus | ATCC17749 | +++ | Красные мелкие колонии |
| Non-01 Vibrio cholerae | - | +++ | Красные |
| Vibrio vulnificus | АТСС 27562 | +++ | Красные |
Применения
Контроль качества
Комплектация
- Упаковка 10 шт/уп.
Мы поможем вам подобрать и купить необходимое оборудование для лаборатории. Компания «МИЛЛАБ» работает с производителями напрямую, потому у нас объективные цены на всю продукцию и устройства!
Компания МИЛЛАБ предлагает услуги собственной сервисной службы, которая обеспечивает бесперебойную эксплуатацию оборудования, поставляемого нашей компанией, профессиональное сервисное обслуживание для максимального использования всех функциональных возможностей оборудования:
1. Выполнение пуско-наладочных работ лабораторного и технологического оборудования.
2. Обучение операционного персонала наших клиентов.
3. Гарантийное обслуживание в соответствии с требованиями предприятия-изготовителя.
4. Ремонт лабораторного оборудования.
5. Ремонт испытательного и технологического оборудования, в том числе заправка хладагентами термостатов, климатических камер и морозильных шкафов.
6. Техническое/регламентное обслуживание поставляемого оборудования.
7. Валидация оборудования для фармацевтических производителей.
8. Поставка оригинальных запчастей.
Мы работаем с юридическими и физическими лицами по безналичному расчету.
После уточнения всех необходимых деталей, менеджер вышлет вам счет на оплату по электронной почте.
Счет оплачивается через банк.
Для физических лиц предоставляется кассовый чек.
Доставка осуществляется по России и странам СНГ транспортными компаниями Деловые Линии и Желдорэкспедиция.
Если вы предпочитаете работать с другой транспортной компанией, необходимо указать в заявке название компании, сайт.
Точная стоимость доставки рассчитывается менеджером при подтверждении заказа в зависимости от характеристик оборудования и населенного пункта места назначения.
Вы можете забрать оборудование сами с нашего склада, который расположен по адресу г. Мытищи, Московская обл, ул. Силикатная , д. 19, стр. 16.
Для самовывоза необходимо предварительно согласовать с оператором склада дату и время получения товара.
Для получения товара необходимо предоставление доверенности организации, а для получения товара при оплате физическим лицом необходим паспорт.
Вы просматривали
Вы можете не печатать документ полностью, а выбрать страницы с описанием интересующих вас моделей в параметрах печати

.png)

.png)



.png)
.png)
.png)



.jpg)
